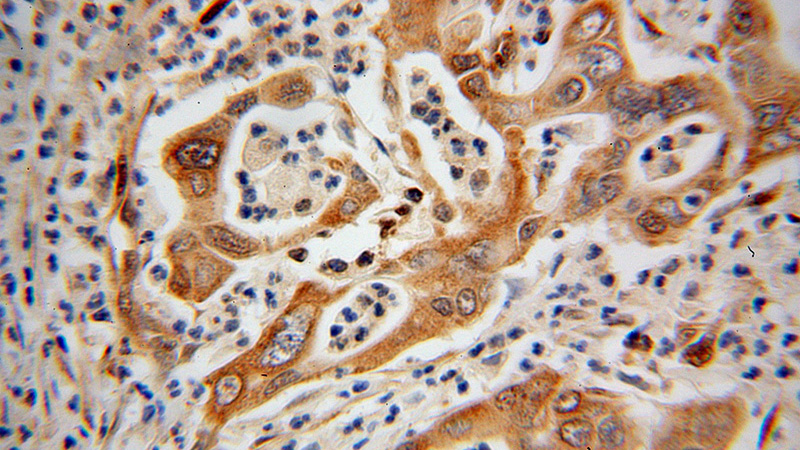
Immunohistochemical of paraffin-embedded human pancreas cancer using Catalog No:111944(ISYNA1 antibody) at dilution of 1:100 (under 40x lens)

-
Product Name
ISYNA1 antibody
- Documents
-
Description
ISYNA1 Rabbit Polyclonal antibody. Positive IF detected in HepG2 cells. Positive IHC detected in human pancreas cancer tissue. Positive WB detected in HepG2 cells. Observed molecular weight by Western-blot: 61kd
-
Tested applications
ELISA, WB, IHC, IF
-
Species reactivity
Human,Mouse,Rat; other species not tested.
-
Alternative names
hINO1 antibody; hIPS antibody; Ino1 antibody; INOS antibody; IPS antibody; IPS 1 antibody; ISYNA1 antibody; MI 1 P synthase antibody; MIP synthase antibody
-
Isotype
Rabbit IgG
-
Preparation
This antibody was obtained by immunization of ISYNA1 recombinant protein (Accession Number: NM_016368). Purification method: Antigen affinity purified.
-
Clonality
Polyclonal
-
Formulation
PBS with 0.02% sodium azide and 50% glycerol pH 7.3.
-
Storage instructions
Store at -20℃. DO NOT ALIQUOT
-
Applications
Recommended Dilution:
WB: 1:200-1:2000
IHC: 1:20-1:200
IF: 1:20-1:200
-
Validations

HepG2 cells were subjected to SDS PAGE followed by western blot with Catalog No:111944(ISYNA1 antibody) at dilution of 1:400

Immunohistochemical of paraffin-embedded human pancreas cancer using Catalog No:111944(ISYNA1 antibody) at dilution of 1:100 (under 10x lens)
Immunohistochemical of paraffin-embedded human pancreas cancer using Catalog No:111944(ISYNA1 antibody) at dilution of 1:100 (under 40x lens)

Immunofluorescent analysis of HepG2 cells, using ISYNA1 antibody Catalog No:111944 at 1:50 dilution and Rhodamine-labeled goat anti-rabbit IgG (red). Blue pseudocolor = DAPI (fluorescent DNA dye).
-
Background
Myo-inositol 3-phosphate synthase (ISYNA1/IP synthase) is a rate-limiting enzyme that catalyzes the first step in the biosynthesis of all inositol containing compounds. It converts glucose 6-phosphate to Myo-inositol 3-phosphate.(PMID:21841945). The native enzyme is typically a homotrimermade up of 68-kDa subunits in mammalian cells and a homotetramer in yeast and plant cells. There are three new isoforms of 62, 43, and 16kDa detected suggesting ISYNA1 is a completely different holoenzyme. But only the brain and testis manifest the 68-kDa isoform, whereas the pancreas has a slightly smaller isoformat 67 kDa. The intestine has a completely unique isoformprofile comprising 62,43, 20kDa isoforms(PMID:19188364).
-
References
- Cao S, Guo X, Zhou Z, Sha J. Comparative proteomic analysis of proteins involved in oocyte meiotic maturation in mice. Molecular reproduction and development. 79(6):413-22. 2012.
- Yu K, Yang J, Wang F. Ethanol supports macrophage recruitment and reinforces invasion and migration of Lewis lung carcinoma. Alcoholism, clinical and experimental research. 38(10):2597-606. 2014.
Related Products / Services
Please note: All products are "FOR RESEARCH USE ONLY AND ARE NOT INTENDED FOR DIAGNOSTIC OR THERAPEUTIC USE"
